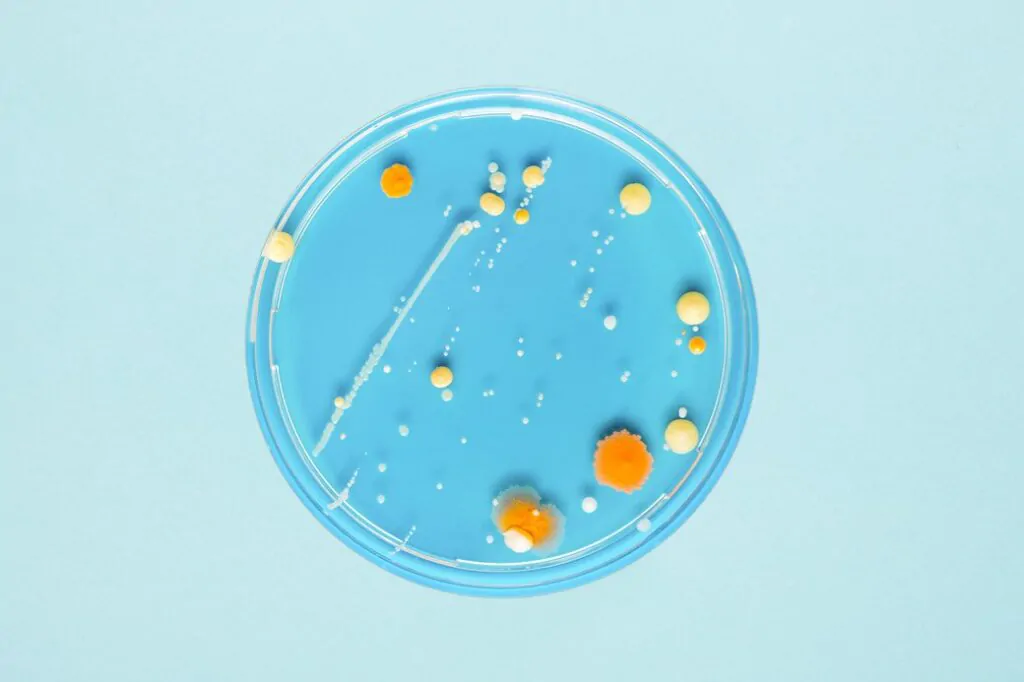
Мікробіом

А ви знали, що більше половини клітин у вашому організмі не є людськими?
І це не жарт, адже за останніми даними з усіх клітин в людському тілі лише 43% - це, власне, клітини людини.
А 57% - це біля 39 трильйонів бактерій, а також архей, грибків та вірусів.
Якщо ж рахувати по масі, то в тілі дорослої людини в середньому близько півтора кілограми мікробів. Це робить наш "мікрозоопарк" одним з найбільших органів, який за вагою конкурує з мозком і лише трохи поступається печінці.
Було б наївно думати, що така кількість мікробів в нашому тілі ніяк не взаємодіє з організмом і не впливає на його роботу...

Вивчення мікробіома - а саме так називається сукупність мікроорганізмів, що живуть всередині і на поверхні тіла - почалося порівняно недавно, по суті, всього 15 років тому. Це означає, що більшість проведених на сьогодні досліджень носять попередній характер і є досить скромними за масштабом: у них брали участь лише десятки мишей або людей.
Однак, чим більше вчені досліджують мікробів, що живуть в і на людському тілі, тим більше вони дізнаються про найпотужніший вплив цих крихіток на наш зовнішній вигляд, поведінку, здоров'я, а також на образ думок і почуття.
Навіть дивно, як ми примудрялися пояснювати процеси, що відбуваються всередині нас, лікувати хвороби, розробляти дієти, вивчати психологію без урахування цього сусідства!
Тож перед вами основні факти, які варто знати про свого найближчого сусіда:
Вороги чи друзі?
Не всі мікроби патогенні. Є корисні, а також ті, які приносять шкоду, якщо виявляються в недозволеному місці або їх кількість різко зросла. Корисні бактерії допомагають запобігти набору ваги, сприяють кращій засвоюваності їжі, забезпечують профілактику появи каменів у нирках. Є й "погані хлопці" типу Clostridium perfringens і кишкової палички E.coli, що здатні викликати захворювання шлунково-кишкового тракту.
Корисні бактерії кишечника дозволяють правильно перетравлювати і поглинати поживні речовини, а деякі з них допомагають боротися із шкідливими мікробами. Більшість бактерій порожнини рота запобігають розмноженню в ротовій порожнині шкідливих організмів. А мікроорганізми на нашій шкірі допомагають запобігти колонізації шкіри патогенами.
Звідки у нас береться мікробіом?
Якщо раніше вважалося, що дитина в утробі матері стерильна, сьогодні відомо, що бактерії присутні в плаценті, навколоплідних водах і пуповинній крові матері. Але по-справжньому «серйозний» контакт з бактеріями доводиться на час пологів. Бактерії, які ми отримуємо при народженні, активують нашу імунну систему.
На початковий склад мікроорганізмів в організмі новонародженого впливає і те, яким чином він з'явився на світ: природним шляхом або за допомогою кесаревого розтину. В другому випадку у дитини буде інша мікрофлора, а також може спостерігатися низька бактеріальна різноманітність протягом перших 12 місяців життя.
Мікробіом активно змінюється протягом перших двох років і стабілізується в трирічному віці. Він продовжує змінюватися все життя під дією навколишнього середовища, антибіотиків, дієт і стресу.

На що впливає мікробіом?
На імунітет
Фахівці стверджують, що люди, які в дитинстві контактували c різноманітними мікробними спільнотами - завдяки братам і сестрам, домашнім тваринам, життю на фермі, - як правило, мають більш здорову імунну систему.
І цьому є логічне пояснення - коли наша імунна система в дитинстві «простоює», не наражаючись на атаку бактерій і вірусів, які мільйони років еволюціонували разом з людиною, то потім вона надто гостро реагує на найменші подразники.
Сучасна гігієнічна гіпотеза стверджує: контакт з непатогенними мікробами, що містяться в грязі і в пилу, а також спілкування з найрізноманітнішими здоровими людьми і тваринами може бути хорошим профілактичним заходом виникнення алергії.
На темперамент
Одне з досліджень показало, що навіть така вроджена, на перший погляд, якість, як темперамент немовляти, може залежати від того, чи належить більшість бактерій в його кишечнику до одного роду: чим більше біфідобактерій, тим більш життєрадіснішою буде дитина.
На настрій і психічне здоров'я
Групи дослідників вважають, що вони от-от здійснять революцію і почнуть застосовувати "мікроби настрою", або "психобіотики" для поліпшення психічного здоров'я.
Дослідження, що дало поштовх усій цій концепції, провели в Університеті Кюсю в Японії. Науковці продемонстрували, що організми "стерильних" мишей (яких вирощували без контакту з мікробами) викидають у кров удвічі більше гормону стресу порівняно зі звичайними мишами. Тварини були ідентичними в усьому, крім мікробів. Цей факт промовисто свідчив про те, що різниця між ними була наслідком діяльності мікроорганізмів.
Ще один експеримент, в якому знову за всіх віддувалися гризуни, був проведений в 2016 році в Ірландському національному університеті.
Дослідники розділили 28 лабораторних щурів на дві групи. Експериментальній групі пересадили трансплантати кишкової мікрофлори від трьох чоловіків, які страждають важкою депресією, а контрольній групі - від трьох здорових чоловіків.
Виявилося, що кишковий мікробіом людей, які страждають депресією, вводив у депресію і щурів.
У порівнянні з контрольними тваринами у них спостерігалася втрата інтересу до діяльності, що приносить задоволення (у щурів це визначають по тому, наскільки часто вони хочуть пити солодку воду), і підвищена тривожність, що виражалася в прагненні уникати відкритих або незнайомих ділянок лабораторного лабіринту.
На апетит і переваги в їжі
В останні кілька років з'являється все більше свідчень того, що бактерії можуть виробляти білки, схожі з нашими гормонами голоду і насичення.
Є і вказівки на те, що бактерії можуть змусити людину віддавати перевагу тій чи іншій їжі в залежності від потрібних їм - бактеріям - речовин. Можливо, це їх еволюційний інструмент: здатність керувати харчовою поведінкою господаря, щоб виживати, іноді, на жаль, роблячи це на шкоду його фігурі.
Проте тепер, з'їдаючи о першій годині ночі пиріжок, можна заспокоювати себе думкою, що ви тут не винні - вас змусили бактерії! ;)
Є й гарні новини: В 2019 році дослідники з Університету штату Юта визначили особливий вид кишкових бактерій Clostridia, який запобігає ожирінню у мишей. Вчені вважають, що ці ж мікроби можуть аналогічним чином контролювати вагу у людей.
На спортивні результати
А ця новина має порадувати спортсменів: ви зможете покращити свої спортивні показники, просто запозичивши особливі кишкові мікроби у досвідченого спортсмена.
Цю гіпотезу успішно підтвердили в 2015 році вчені з Гарвардського університету.
Протягом двох тижнів вони щодня аналізували зміни мікробіома 15 бігунів, які брали участь в Бостонському марафоні, - дослідження почали за тиждень до забігу і закінчили тиждень по тому - і порівняли їх зі зразками аналізів, зібраними також за два тижні у десяти осіб з контрольної групи, які не займаються бігом.
Дослідники виявили, що через кілька днів після марафону в аналізах, взятих у бігунів, містилося значно більше бактерій Veillonella atypica, ніж в аналізах учасників контрольної групи.
Цей експеримент - чудовий приклад того, що дає нам симбіоз мікробіома і нашого організму. Вейлонелла процвітає, коли людина, її носій, в результаті фізичного навантаження виробляє лактат, яким харчується бактерія. А бактерія, в свою чергу, приносить користь людині, перетворюючи лактат на пропіонат, що впливає на працездатність «господаря», адже пропіонат, в числі іншого, підвищує частоту скорочень серця і покращує кисневий обмін, а також, можливо, перешкоджає розвитку запалень в м'язах.

Де живе мікробіом?
Бактерії не розподілені по тілу рівномірно - і щільність, і склад мікробного «населення» відрізняється від одного органу до іншого. Настільки, що мікробні спільноти будуть різними навіть на пальцях правої і лівої руки або на зубах і в слині. Більш того, чисельність бактерій на тій чи іншій частині тіла необов'язково корелює з їх різноманіттям - буває рівно навпаки. Наприклад, у нас під пахвами і на лобі мешкає численне, проте однорідне співтовариство. А ось на долонях і передпліччях чисельність колоній не надто висока, зате там багато різних видів.
Найбільша ж кількість мікробної спільноти передбачувано проживає в нашому кишечнику - там нараховується біля 1000 різних видів бактерій.
Як стати гарним сусідом своєму мікробіому?
Якщо мікроорганізми так важливі і настільки сильно впливають на нас, чи є спосіб нам самим на них впливати?
Насправді, ми робимо це постійно. Змінюючи співвідношення зернових продуктів і білка в раціоні, відмовляючись від алкоголю, приймаючи антибіотики, ми діємо на свою мікробіоту.
У відкритих джерелах можна знайти купу порад про те, як поліпшити власний мікробіом. Вони розумні, досить прості і підтверджені наукою.
Ось топ-10 найефективніших:

1. Їжте ферментовані продукти і пробіотики.
Побіотики - це живі бактерії, які можна знайти в ферментованих продуктах або у вигляді біодобавок. Дослідження припускають, що прийом пробіотиків сприяє здоров'ю кишкової флори і скорочення запальних процесів. Приклади продуктів, що містять пробіотики:
- йогурт або кефір;
- квашена капуста і ферментовані овочі;
- місо (ферментована паста на основі соєвих бобів, рису, ячменю чи пшениці), комбуча (знайомий багатьом з дитинства "чайний гриб") і темпі (ферментована соя).
2. Не забувайте про пребіотики (клітковину).
Пребіотики - частина деяких продуктів, яку ми не можемо перетравити та яка при цьому забезпечує поживними речовинами багато бактерій. Служачи їжею для різних видів мікроорганізмів в нашому кишечнику, пребіотики пом'якшують конкуренцію між ними і таким чином стимулюють різноманітність.
А, як ми пам'ятаємо, різноманітність мікробіома - це ключовий критерій його здоров'я.
- Продукти з пребіотиками: овочі, фрукти, ягоди, бобові, цільнозернові продукти. Клітковина міститься в зовнішній оболонці зерна - висівках, а в продуктах з білої муки і в очищеному рисі її істотно менше.
3. Знижуйте рівень стресу.
Навіть короткочасний стрес негативно впливає на кишкову флору, сприяє збільшенню запальних процесів, діє на імунну систему. При цьому до стрес-факторів належать не тільки сильні психологічні переживання, а й агресивні умови середовища (сильний холод, спека або шум), нестача сну і порушення циркадних ритмів.
4. Уникайте прийому антибіотиків без необхідності.
Багато дослідників порівнюють антибіотики з хімічною зброєю або напалмом: вони вражають безліч живих мікроорганізмів усередині нас, знижуючи їх різноманітність і викликаючи наслідки, які буває складно передбачити. Після прийому деяких сильних антибіотиків окремі види бактерій не відновлюються і через 6 місяців.
До речі, нагадаємо, що про шкоду антибіотиків ми нещодавно писали тут.
5. Займайтеся спортом.
Про чудову бактерію Veillonella atypica ми вже згадували вище. Однак регулярні фізичні навантаження також пов'язують зі змінами в складі і активності інших кишкових бактерій, а професійні спортсмени можуть похвалитися високим різноманітністю своєї флори.
6. Добре висипайтеся.
Відносини між бактеріями і сном - велика і складна тема, і причинно-наслідкові зв'язки тут поки не до кінця встановлено. Але судячи з усього, якість нашого сну здатна впливати на баланс мікроорганізмів в кишечнику, а ті, в свою чергу, беруть участь в регуляції сну. Тому здорові практики в питаннях відпочинку - спати 7-9 годин, відходити до сну в один і той же час - наші кращі друзі.
7. Не куріть.
Куріння - стрес-фактор для мікробіома, і швидше за все (вченим поки доводиться з обережністю говорити про причинно-наслідкові зв'язки), воно негативно позначається на кількості бактерій, які вважаються корисними для нас. Причому це стосується мікроорганізмів, що живуть не тільки в кишечнику, але й у ротовій порожнині і дихальних шляхах. Дослідження показують, що відмова від куріння збільшує різноманітність в мікробному співтоваристві і асоціюється зі зниженням серцевого ритму, систолічного тиску і рівня С-реактивного білка (маркера запалення).
8. Вживайте їжу з поліфенолами.
Поліфеноли входять до складу ряду рослин і вважаються корисними для здоров'я сполуками. А ще вони не завжди повністю засвоюються в тонкому кишечнику, а значить, надходять в товстий, де служать їжею для мікроорганізмів, стимулюючи їх активність.
- Продукти з поліфенолами: какао-боби, темний шоколад, чорний і зелений чай, шкірка винограду, чорниця, брокколі.
9. Їжте різноманітну рослинну їжу.
У деяких джерелах можна зустріти твердження, що для мікробіома ідеальна вегетаріанська дієта. Але за словами епідеміолога, відомого дослідника мікробіома Тіма Спектора, ключ до різноманітного мікробіома не вегетаріанство/веганство, або відмова від глютену і лактози, або будь-яка інша харчова «релігія». Головне - кількість рослинних джерел їжі, які людина споживає щотижня.
Важливіше не поглинати по три кілограми брокколі щодня, а їсти максимально різноманітно: різне насіння, трави, спеції, фрукти, ягоди, овочі, горіхи і так далі. Кожне джерело їжі «годує» ті чи інші мікроорганізми, а всі разом вони забезпечують здоров'я мікробіома.
10. Практикуйте інтервальне голодування.
Дослідження виявили, що голодування, з одного боку, призводить до зниження чисельності деяких бактерій, пов'язаних із захворюваннями, наприклад, Fusobacterium, що сприяє розвиткові колоректального раку. З іншого боку, інтервальне голодування чи піст тягнуть із собою зміни в метаболізмі і скорочення маркерів запалення, - процеси в яких також бере участь мікробіом.
Інтервальне голодування також асоціюють із зменшенням зайвої ваги, поліпшенням серцево-судинних показників, тиску, когнітивних функцій і загального самовідчуття. Чому різке обмеження калорій або інтервальне голодування саме так впливають на стан здоров'я і мікробіоту, поки складно сказати. Але схоже, що вони дійсно допомагають відроджувати різноманітність бактерій, посилювати протидію «поганим» типам бактерій і відновлювати цілісність епітелію кишечника.
Як бачите, для ефективного симбіозу людини і його "мікрозоопарка" не потрібно докладати надзусиль або ж діяти собі на шкоду. Це ще раз доводить - мікробіом нам не тільки "сусід", але і "друг", який хоче, щоб ми жили разом довго, здорОво і щасливо.
Цілком можливо, подальше вивчення мікробіома - разом з новими генетичними технологіями - призведе до справжньої революції в медицині. Але навіть те, що відомо зараз, вже може допомогти нам змінити своє життя на краще!
За матеріалами з мережі Інтернет
P.S. Також не забувайте підписуватися на нашу групу у Telegram – t.me/TASlife, на нашу сторінку в Instagram, та на нашу сторінку у Facebook – facebook.com/taslifeofficial













Ярослав
Цікава інформація. Головне правильно використовувати знання.
Займатися своїм здоров’ям дешевше і приємніше ніж будь яке лікування.
life TAS
Дякуємо за Ваш відгук, Ярославе! І цілком з Вами погоджуємось.